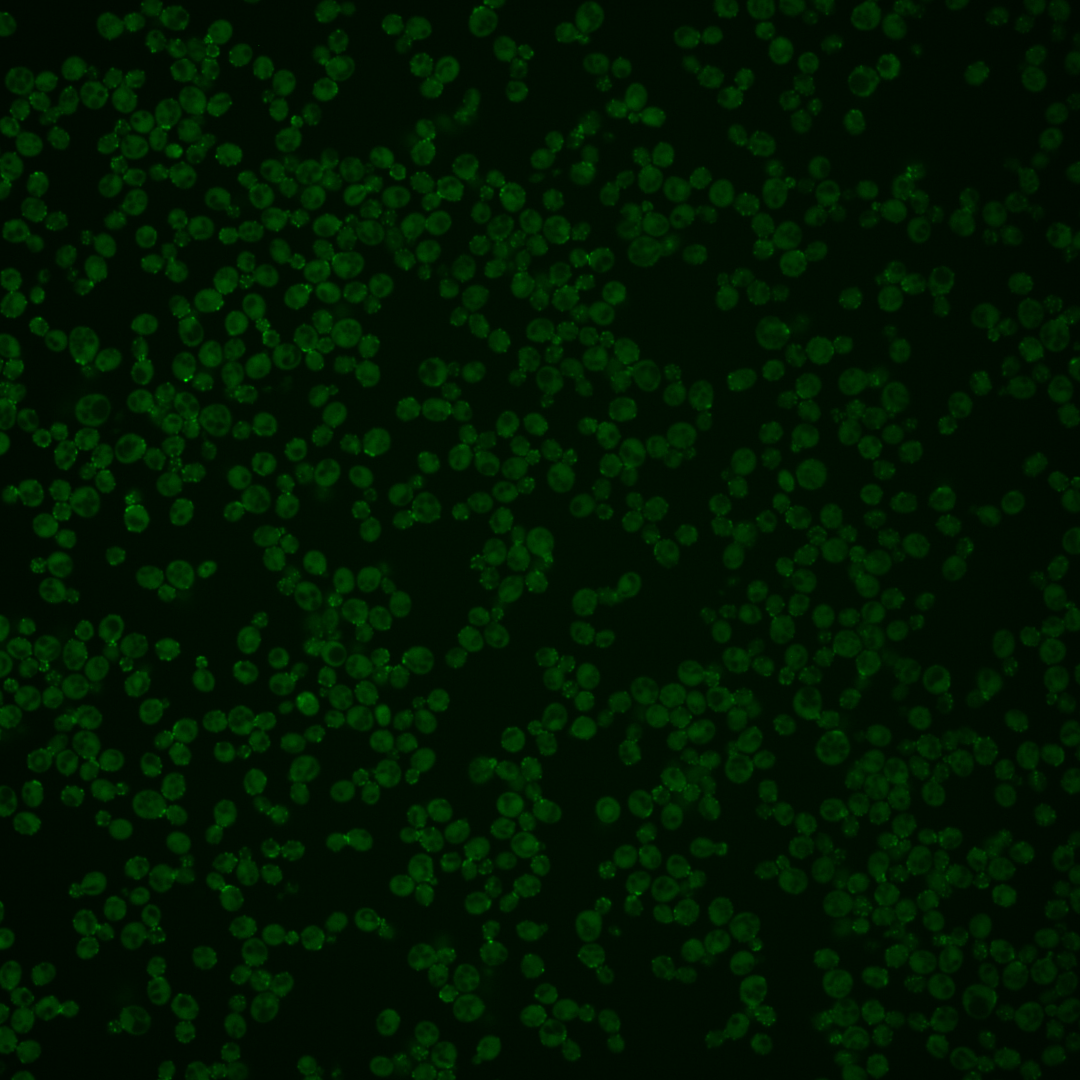
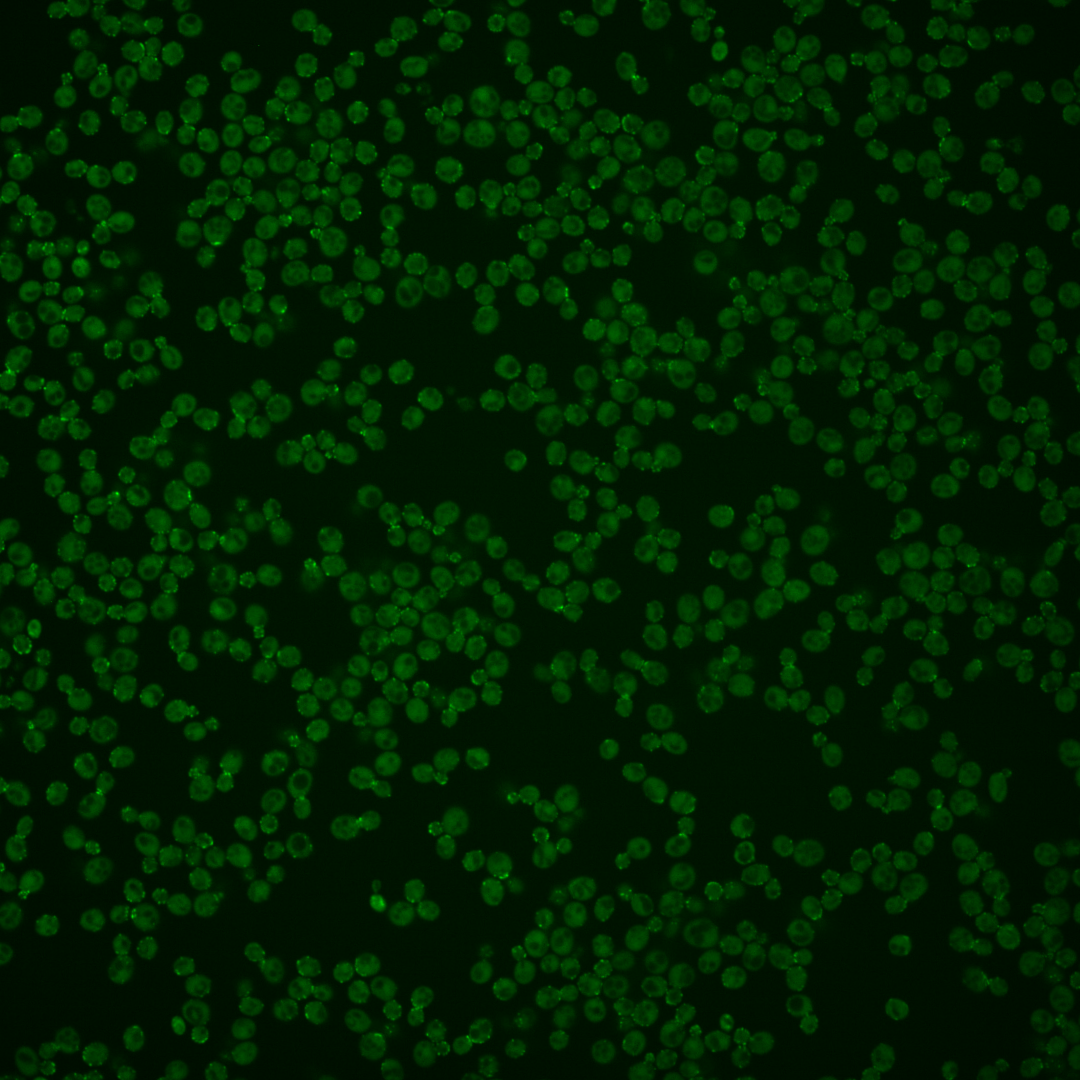
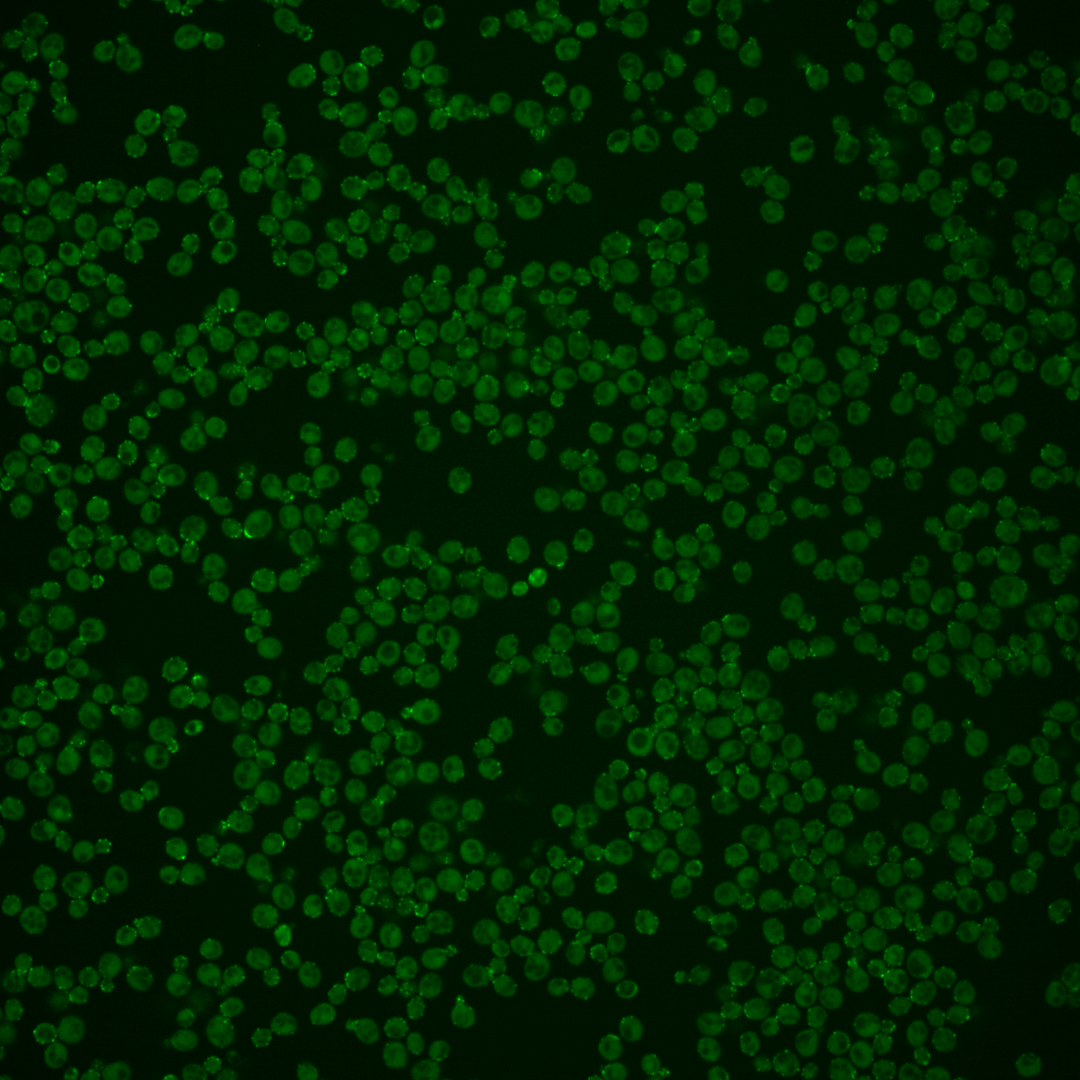

| Standard name | |
|---|---|
| Human Ortholog | |
| Description | SH3 domain protein implicated in regulating actin polymerization; able to recruit actin polymerization machinery through its SH3 domains; colocalizes with cortical actin patches and Las17p; interacts with type I myosins |
Micrographs




















































































Sub-cellular Localization
Yeast GFP Assignment
Protein Abundance
Localization Change
External localization resources
| ensLOC | DeepLoc | |||||||||||||||||||||||
|---|---|---|---|---|---|---|---|---|---|---|---|---|---|---|---|---|---|---|---|---|---|---|---|---|
| Localization | WT1 | WT2 | WT3 | RAP60 | RAP140 | RAP220 | RAP300 | RAP380 | RAP460 | RAP540 | RAP620 | RAP700 | HU80 | HU120 | HU160 | rpd3Δ_1 | rpd3Δ_2 | rpd3Δ_3 | WT1 | WT2 | WT3 | AF100 | AF140 | AF180 |
| Cortical Patches | 12 | 61 | 34 | 86 | 98 | 111 | 131 | – | 121 | 111 | 89 | 118 | 33 | 86 | 103 | 150 | 186 | 98 | 61 | 105 | 81 | 41 | 130 | 133 |
| Bud | 2 | 19 | 10 | 34 | 41 | 32 | 44 | – | 50 | 36 | 29 | 44 | 6 | 26 | 26 | 32 | 32 | 19 | 3 | 5 | 8 | 10 | 23 | 25 |
| Bud Neck | 0 | 0 | 0 | 0 | 0 | 0 | 0 | – | 0 | 0 | 0 | 0 | 0 | 0 | 0 | 0 | 3 | 0 | 2 | 7 | 7 | 8 | 22 | 23 |
| Bud Site | 0 | 2 | 0 | 2 | 2 | 5 | 1 | – | 7 | 4 | 8 | 6 | 0 | 2 | 1 | 8 | 7 | 3 | – | – | – | – | – | – |
| Cell Periphery | 0 | 16 | 14 | 15 | 17 | 15 | 28 | – | 24 | 22 | 25 | 24 | 10 | 29 | 55 | 48 | 49 | 26 | 0 | 3 | 1 | 0 | 2 | 4 |
| Cytoplasm | 1 | 44 | 25 | 43 | 64 | 52 | 81 | – | 60 | 66 | 38 | 48 | 41 | 78 | 78 | 98 | 79 | 69 | 3 | 14 | 8 | 5 | 26 | 52 |
| Endoplasmic Reticulum | 1 | 22 | 7 | 27 | 18 | 41 | 57 | – | 46 | 54 | 49 | 42 | 5 | 19 | 19 | 16 | 19 | 12 | 0 | 1 | 3 | 1 | 1 | 3 |
| Endosome | 0 | 0 | 0 | 0 | 12 | 2 | 15 | – | 10 | 11 | 2 | 11 | 1 | 1 | 0 | 3 | 2 | 5 | 3 | 3 | 6 | 1 | 8 | 6 |
| Golgi | 0 | 3 | 2 | 2 | 7 | 1 | 2 | – | 4 | 5 | 2 | 6 | 1 | 1 | 4 | 41 | 50 | 26 | 0 | 1 | 1 | 0 | 1 | 0 |
| Mitochondria | 3 | 0 | 0 | 1 | 0 | 10 | 25 | – | 56 | 48 | 98 | 76 | 0 | 0 | 1 | 16 | 8 | 2 | 2 | 1 | 4 | 1 | 9 | 5 |
| Nucleus | 0 | 1 | 0 | 1 | 0 | 1 | 0 | – | 1 | 2 | 1 | 1 | 0 | 0 | 1 | 2 | 0 | 6 | 0 | 0 | 0 | 0 | 0 | 0 |
| Nuclear Periphery | 0 | 0 | 0 | 1 | 0 | 0 | 1 | – | 2 | 1 | 0 | 0 | 0 | 0 | 2 | 0 | 0 | 0 | 0 | 0 | 0 | 0 | 0 | 0 |
| Nucleolus | 0 | 0 | 0 | 0 | 1 | 0 | 2 | – | 1 | 0 | 1 | 2 | 0 | 0 | 0 | 0 | 3 | 1 | 0 | 0 | 0 | 0 | 0 | 0 |
| Peroxisomes | 0 | 3 | 2 | 3 | 11 | 8 | 20 | – | 14 | 10 | 4 | 18 | 3 | 9 | 8 | 7 | 7 | 7 | 0 | 1 | 2 | 1 | 0 | 0 |
| SpindlePole | 0 | 2 | 1 | 3 | 12 | 1 | 18 | – | 9 | 14 | 1 | 9 | 4 | 12 | 8 | 22 | 34 | 17 | 0 | 0 | 0 | 0 | 1 | 1 |
| Vac/Vac Membrane | 0 | 0 | 2 | 2 | 13 | 0 | 5 | – | 6 | 9 | 1 | 6 | 1 | 1 | 0 | 12 | 15 | 12 | 0 | 0 | 0 | 0 | 2 | 1 |
| Unique Cell Count | 16 | 128 | 69 | 160 | 205 | 200 | 301 | 280 | 276 | 223 | 282 | 81 | 192 | 218 | 313 | 340 | 212 | 78 | 148 | 129 | 76 | 235 | 267 | |
| Labelled Cell Count | 19 | 173 | 97 | 220 | 296 | 279 | 430 | 411 | 393 | 348 | 411 | 105 | 264 | 306 | 455 | 494 | 303 | 78 | 148 | 129 | 76 | 235 | 267 | |
Yeast GFP Assignment
Protein Abundance
| Screen | WT1 | WT2 | WT3 | RAP60 | RAP140 | RAP220 | RAP300 | RAP380 | RAP460 | RAP540 | RAP620 | RAP700 | HU80 | HU120 | HU160 | rpd3Δ_1 | rpd3Δ_2 | rpd3Δ_3 | AF100 | AF140 | AF180 |
|---|---|---|---|---|---|---|---|---|---|---|---|---|---|---|---|---|---|---|---|---|---|
| Mean Cell GFP Intensity (1e-4) | 8.5 | 9.9 | 9.6 | 9.2 | 9.6 | 8.2 | 8.2 | – | 7.3 | 7.5 | 7.0 | 7.4 | 9.7 | 9.7 | 9.9 | 12.9 | 13.4 | 12.8 | 8.7 | 9.0 | 9.2 |
| Std Deviation (1e-4) | 1.1 | 1.5 | 1.6 | 1.5 | 1.7 | 1.5 | 1.5 | – | 1.5 | 1.6 | 1.4 | 1.7 | 1.4 | 1.4 | 1.5 | 2.5 | 2.4 | 2.4 | 1.2 | 1.4 | 1.4 |
| Intensity Change (Log2) | – | – | – | -0.08 | -0.01 | -0.24 | -0.23 | – | -0.41 | -0.35 | -0.47 | -0.39 | 0.01 | 0.01 | 0.04 | 0.42 | 0.47 | 0.41 | -0.15 | -0.1 | -0.07 |
Localization Change
| Localization | RAP60 | RAP140 | RAP220 | RAP300 | RAP380 | RAP460 | RAP540 | RAP620 | RAP700 | HU80 | HU120 | HU160 | rpd3Δ_1 | rpd3Δ_2 | rpd3Δ_3 |
|---|---|---|---|---|---|---|---|---|---|---|---|---|---|---|---|
| Cortical Patches | 0.6 | -0.2 | 0.9 | -0.9 | – | -0.9 | -1.4 | -1.4 | -1.1 | -1.0 | -0.6 | -0.3 | -0.2 | 0.8 | -0.4 |
| Bud | 1.2 | 1.0 | 0.3 | 0 | – | 0.7 | -0.3 | -0.3 | 0.2 | -1.4 | -0.2 | -0.6 | -1.0 | -1.3 | -1.3 |
| Bud Neck | 0 | 0 | 0 | 0 | – | 0 | 0 | 0 | 0 | 0 | 0 | 0 | 0 | 0 | 0 |
| Bud Site | 0 | 0 | 0 | 0 | – | 0 | 0 | 0 | 0 | 0 | 0 | 0 | 0 | 0 | 0 |
| Cell Periphery | -2.3 | -2.7 | -3.0 | -2.6 | – | -2.8 | -3.0 | -1.9 | -2.8 | -1.3 | -1.0 | 0.8 | -1.0 | -1.2 | -1.7 |
| Cytoplasm | -1.4 | -0.8 | -1.6 | -1.5 | – | -2.6 | -2.1 | -3.4 | -3.5 | 1.8 | 0.6 | -0.1 | -0.8 | -2.3 | -0.6 |
| Endoplasmic Reticulum | 1.3 | -0.3 | 1.9 | 1.7 | – | 1.3 | 1.8 | 2.2 | 1.0 | -0.9 | -0.1 | -0.4 | 0 | 0 | 0 |
| Endosome | 0 | 0 | 0 | 0 | – | 0 | 0 | 0 | 0 | 0 | 0 | 0 | 0 | 0 | 0 |
| Golgi | 0 | 0 | 0 | 0 | – | 0 | 0 | 0 | 0 | 0 | 0 | 0 | 2.4 | 2.7 | 2.3 |
| Mitochondria | 0 | 0 | 0 | 0 | – | 4.1 | 3.7 | 6.8 | 4.9 | 0 | 0 | 0 | 0 | 0 | 0 |
| Nucleus | 0 | 0 | 0 | 0 | – | 0 | 0 | 0 | 0 | 0 | 0 | 0 | 0 | 0 | 0 |
| Nuclear Periphery | 0 | 0 | 0 | 0 | – | 0 | 0 | 0 | 0 | 0 | 0 | 0 | 0 | 0 | 0 |
| Nucleolus | 0 | 0 | 0 | 0 | – | 0 | 0 | 0 | 0 | 0 | 0 | 0 | 0 | 0 | 0 |
| Peroxisomes | 0 | 0 | 0 | 0 | – | 0 | 0 | 0 | 0 | 0 | 0 | 0 | 0 | 0 | 0 |
| SpindlePole | 0 | 0 | 0 | 0 | – | 0 | 0 | 0 | 0 | 0 | 0 | 0 | 0 | 2.3 | 0 |
| Vacuole | 0 | 0 | 0 | 0 | – | 0 | 0 | 0 | 0 | 0 | 0 | 0 | 0 | 0 | 0 |
External localization resources
Images






























Protein Concentration and Protein Localization Data
| R1 | R2 | R3 | ||||||||||||||||
|---|---|---|---|---|---|---|---|---|---|---|---|---|---|---|---|---|---|---|
| G1 Pre-START | G1 Post-START | S/G2 | Metaphase | Anaphase | Telophase | G1 Pre-START | G1 Post-START | S/G2 | Metaphase | Anaphase | Telophase | G1 Pre-START | G1 Post-START | S/G2 | Metaphase | Anaphase | Telophase | |
| Concentration | 2.0953 | 3.4087 | 2.822 | 3.4015 | 1.861 | 3.2044 | 4.633 | 5.642 | 5.2213 | 4.8746 | 5.1258 | 5.4166 | 4.6398 | 5.01 | 4.4194 | 4.1453 | 4.5359 | 4.6068 |
| Actin | 0.7043 | 0.5886 | 0.738 | 0.8475 | 0.8296 | 0.854 | 0.6631 | 0.4642 | 0.7192 | 0.6562 | 0.7584 | 0.7854 | 0.741 | 0.5332 | 0.7324 | 0.7239 | 0.8813 | 0.8343 |
| Bud | 0.0018 | 0.0027 | 0.0298 | 0.0113 | 0.0062 | 0.0014 | 0.0032 | 0.007 | 0.0308 | 0.0333 | 0.0071 | 0.0011 | 0.0059 | 0.0076 | 0.0401 | 0.0401 | 0.0134 | 0.001 |
| Bud Neck | 0.0169 | 0.0055 | 0.0127 | 0.0009 | 0.0059 | 0.1035 | 0.0234 | 0.0115 | 0.012 | 0.0021 | 0.0024 | 0.1553 | 0.044 | 0.0091 | 0.009 | 0.0011 | 0.0281 | 0.1206 |
| Bud Periphery | 0.0024 | 0.002 | 0.0382 | 0.0593 | 0.0244 | 0.0023 | 0.0063 | 0.0127 | 0.064 | 0.1548 | 0.0552 | 0.0038 | 0.0077 | 0.0065 | 0.067 | 0.0962 | 0.0643 | 0.0031 |
| Bud Site | 0.0607 | 0.3045 | 0.0711 | 0.0014 | 0.0023 | 0.0016 | 0.0591 | 0.341 | 0.0565 | 0.0036 | 0.0016 | 0.0032 | 0.0421 | 0.2602 | 0.0237 | 0.0069 | 0.0043 | 0.0012 |
| Cell Periphery | 0.0017 | 0.0016 | 0.0007 | 0.0007 | 0.0003 | 0.0007 | 0.0044 | 0.005 | 0.0014 | 0.0011 | 0.0041 | 0.001 | 0.0061 | 0.0015 | 0.0015 | 0.0009 | 0.0028 | 0.0008 |
| Cytoplasm | 0.0174 | 0.0468 | 0.0186 | 0.003 | 0.003 | 0.0171 | 0.0373 | 0.1135 | 0.0382 | 0.0436 | 0.0048 | 0.0107 | 0.0305 | 0.1223 | 0.0536 | 0.0323 | 0.002 | 0.0103 |
| Cytoplasmic Foci | 0.0525 | 0.019 | 0.0127 | 0.0117 | 0.018 | 0.0097 | 0.0342 | 0.0136 | 0.0159 | 0.0159 | 0.0118 | 0.007 | 0.0305 | 0.021 | 0.0204 | 0.0205 | 0.001 | 0.0055 |
| Eisosomes | 0.0017 | 0.0009 | 0.0004 | 0.0004 | 0.0008 | 0.0007 | 0.0021 | 0.0006 | 0.0013 | 0.0009 | 0.007 | 0.001 | 0.0017 | 0.0004 | 0.0009 | 0.0006 | 0.0003 | 0.0009 |
| Endoplasmic Reticulum | 0.004 | 0.0009 | 0.0011 | 0.0001 | 0.0003 | 0.0005 | 0.0079 | 0.0013 | 0.0005 | 0.0005 | 0.0011 | 0.0003 | 0.0024 | 0.0014 | 0.0032 | 0.0042 | 0.0001 | 0.0017 |
| Endosome | 0.0219 | 0.0061 | 0.0058 | 0.0037 | 0.0027 | 0.0004 | 0.0424 | 0.0033 | 0.0072 | 0.0076 | 0.0428 | 0.0039 | 0.0096 | 0.0048 | 0.0102 | 0.0149 | 0.0001 | 0.0041 |
| Golgi | 0.0158 | 0.0066 | 0.0069 | 0.058 | 0.0109 | 0.0029 | 0.0227 | 0.0046 | 0.0138 | 0.0198 | 0.0065 | 0.0072 | 0.0114 | 0.0172 | 0.0112 | 0.0101 | 0.0011 | 0.0082 |
| Lipid Particles | 0.0229 | 0.0025 | 0.0089 | 0.0001 | 0.0277 | 0.0005 | 0.0274 | 0.0005 | 0.0031 | 0.0026 | 0.0161 | 0.0063 | 0.0099 | 0.0005 | 0.0039 | 0.0076 | 0 | 0.0015 |
| Mitochondria | 0.012 | 0.0043 | 0.0349 | 0.0009 | 0.0016 | 0.0003 | 0.0092 | 0.0095 | 0.0194 | 0.0476 | 0.0036 | 0.0065 | 0.0053 | 0.0005 | 0.0024 | 0.0021 | 0.0002 | 0.0008 |
| None | 0.0174 | 0.0031 | 0.002 | 0.0001 | 0.0005 | 0.0008 | 0.0134 | 0.0065 | 0.0038 | 0.0021 | 0.0009 | 0.0001 | 0.0237 | 0.0007 | 0.0062 | 0.005 | 0 | 0.0002 |
| Nuclear Periphery | 0.0027 | 0.0001 | 0.0003 | 0 | 0.0001 | 0 | 0.0112 | 0.0003 | 0.0002 | 0.0002 | 0.0017 | 0.0001 | 0.0056 | 0.0003 | 0.002 | 0.0036 | 0 | 0.0028 |
| Nucleolus | 0.0012 | 0.0001 | 0.0006 | 0 | 0 | 0 | 0.0011 | 0.0001 | 0.0001 | 0 | 0.0007 | 0.0001 | 0.0012 | 0 | 0.0004 | 0.0001 | 0 | 0 |
| Nucleus | 0.0015 | 0.0001 | 0.0004 | 0 | 0 | 0 | 0.0041 | 0.0005 | 0.0002 | 0.0002 | 0.0008 | 0.0001 | 0.0011 | 0.0003 | 0.0007 | 0.0006 | 0 | 0.0002 |
| Peroxisomes | 0.0318 | 0.0038 | 0.0153 | 0.0008 | 0.064 | 0.0034 | 0.0157 | 0.003 | 0.0112 | 0.0066 | 0.0641 | 0.006 | 0.0148 | 0.012 | 0.0075 | 0.0248 | 0.0009 | 0.002 |
| Punctate Nuclear | 0.0074 | 0.0002 | 0.0005 | 0 | 0.0013 | 0.0001 | 0.0036 | 0.0003 | 0.0004 | 0.0001 | 0.0005 | 0.0001 | 0.0037 | 0.0003 | 0.0022 | 0.0023 | 0 | 0.0004 |
| Vacuole | 0.0012 | 0.0005 | 0.0007 | 0 | 0.0001 | 0 | 0.006 | 0.0008 | 0.0006 | 0.0005 | 0.0067 | 0.0006 | 0.0009 | 0.0002 | 0.001 | 0.0016 | 0.0001 | 0.0001 |
| Vacuole Periphery | 0.0009 | 0.0001 | 0.0004 | 0 | 0.0001 | 0 | 0.0021 | 0.0002 | 0.0003 | 0.0005 | 0.002 | 0.0003 | 0.0009 | 0.0001 | 0.0003 | 0.0006 | 0 | 0.0003 |
Sequencing Data
| R1 | R2 | |||||||||
|---|---|---|---|---|---|---|---|---|---|---|
| G1 Post-START | S/G2 | Metaphase | Anaphase | Telophase | G1 Post-START | S/G2 | Metaphase | Anaphase | Telophase | |
| Gene Expression | 24.6555 | 16.0766 | 18.4715 | 25.4603 | 28.9582 | 19.1336 | 25.6934 | 29.0202 | 28.5416 | 27.5424 |
| Translational Efficiency | 1.2438 | 1.703 | 1.3537 | 0.9433 | 0.9443 | 1.586 | 0.9498 | 0.8001 | 0.8878 | 0.9953 |
Hit Data
| Dataset | Hit |
|---|---|
| Protein Concentration | ✘ |
| Protein Localization | ✔ |
| Gene Expression | ✘ |
| Translational Efficiency | ✘ |
Endocytosis
| Temp | Actin Patch (Sac6-tdTomato) | Cortical Patch (Sla1-GFP) | Late Endosome (Snf7-GFP) | Vacuole (Vph1-GFP) |
|---|---|---|---|---|
| 37℃ | ||||
| RT |
Cell Cycle Omics
CYCLoPs (Bzz1-GFP)
| Gene / Allele | Actin Patch (Sac6-tdTomato) | Cortical Patch (Sla1-GFP) | Late Endosome (Snf7-GFP) | Vacuole (Sac6-tdTomato) |
|---|
| Gene | Images |
|---|
| Gene | Images |
|---|
Images are not yet available
Images are not yet available